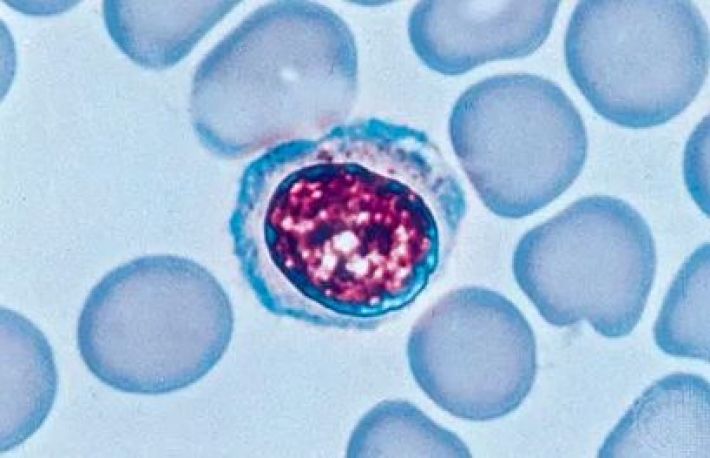

Limfocitele sunt leucocite cu nucleul foarte voluminos. Ele se gasesc in limfa si in sange, avand un rol important in imunitatea organismului. Altfel spus, limfocitele sunt globule albe care ajuta sistemul imunitar sa lupte impotriva infectiilor. Limfocitele sunt de 3 feluri: celule T, celule B si celule natural killer(ucigase). Celulele B produc anticorpi care ataca virusurile invadatoare, bacteriile sau toxinele, in timp ce celulele T si cele natural killer ataca propriile celule devenite compromise.
Cauzele scaderii nivelului de limfocite. Cauzele obisnuite sunt: infectiile virale, alimentatia deficitara, stresul, chimioterapia si utilizarea corticosteroizilor. Oricare ar fi cauza, poti stimula sistemul imunitar sa creasca numarul de limfocite.
Cum sa cresti numarul de limfocite. Alimentatie:
1. Consuma proteine slabe. Proteinele sunt formate din lanturi lungi de aminoacizi, de care corpul are nevoie pentru a produce globule albe. Atunci cand organismul nu primeste suficiente proteine, acesta produce mai putine globule albe. Practic, poti creste productia de limfocite mancand cantitatea potrivita de proteine. Cele mai potricvite proteine slabe sunt: pieptul de pui/de curcan fara piele, pestele, crustaceele, branza de vaci, albusurile si fasolea. Pentru a afla cate proteine trebuie sa consumi pe zi, foloseste un calculator specific. Gasesti cateva site-uri care se ocupa de asa ceva.
2. Evita alimentele bogate in grasimi saturate si trans. Grasimile rele, cum ar fi grasimile saturate si cele trans, ingroasa limfocitele, scazandu-le eficienta. Reducerea consumului de grasimi saturate si trans poate imbunatati sistemul imunitar. In plus, ar trebui sa alegi grasimile mono si polinesaturate. Inlocuieste, asadar, grasimile saturate si trans cu grasimi sanatoase, cum ar fi acizii grasi omega-3, care pot creste numarul de limfocite. Mentine consumul de grasimi la 30% din calorii, doar 5 pana la 10% din acestea fiind grasimi saturate. Poti evita consumul de grasimi trans, ferindu-te de uleiuri hidrogenate, produse de patiserie din comert, alimente prajite, fast-food si margarina.
3. Consuma alimente care contin beta-caroten. Beta-carotenul sustine sistemul imunitar prin cresterea productiei de limfocite. Ca bonus, protejeaza organismul impotriva cancerului, bolilor de inima si accidentului vascular cerebral. Majoritatea medicilor recomanda intre 10 000 si 83 000 IU pe zi, adica minimum 3,000 mcg/zi . Daca mananci cinci sau mai multe portii de legume in fiecare zi, ar trebui sa atingi acest obiectiv. Beta-carotenul este o vitamina solubila in grasimi, asa ca ar trebui sa o consumi cu cel putin 3 grame de grasime pentru a asigura absorbtia. De exemplu, poti inmuia morcovi in hummus sau poti consuma o salata cu un sos cu continut scazut de grasimi, cum ar fi uleiul de masline amestecat cu otet balsamic. Beta-carotenul din alimente este procesat diferit prin suplimente, asa ca nu vei obtine aceleasi beneficii. Sub forma de supliment, beta-carotenul poate provoca rau fumatorilor. Beta-carotenul se gaseste in cartofi dulci, morcovi, spanac, salata romana, dovleac, pepene galben si caise uscate.
4. Mananca alimente care contin zinc. Zincul ajuta la cresterea numarului de celule T si a celulelor natural killer, intarind sistemul imunitar. Corpul are nevoie de zinc pentru a produce limfocite, asa ca trebuie sa atingi cerintele zilnice recomandate. Barbatii ar trebui sa consume cel putin 11 mg de zinc pe zi, in timp ce femeile ar trebui sa manance cel putin 8 mg in aceeasi perioada. Femeile insarcinate ar trebui sa consume cel putin 11 mg de zinc pe zi, in timp ce femeile care alapteaza ar trebui sa consume 12 mg in aceeasi perioada. Alimentele bogate in zinc sunt: stridiile, cerealele fortificate, crabii, carnea de vita, carne de curcan negru si fasolea.
5. Condimenteaza mancarea cu usturoi. Usturoiul creste productia de celule albe. Ca un beneficiu suplimentar, usturoiul este un antioxidant natural. De asemenea, ajuta la prevenirea bolilor cardiovasculare. Poti folosi usturoiu proaspat sau in varianta pudra.
6. Bea ceai verde in fiecare zi. Ceaiul verde sustine sistemul imunitar, luptand impotriva virusurilor ce pot epuiza celulele albe.
Cum sa cresti numarul de limfocite. Vitamine si suplimente:
1. Ia vitamina C. Vitamina C creste productia de celule albe din sange, inclusiv limfocitele. Poti lua vitamina C din alimente, dar si din suplimente. Deoarece corpul nu produce si nu stocheaza vitamina C, ar trebui sa consumi surse de nutrienti in fiecare zi. Cand iei vitamina C, corpul tau foloseste cantitatea de care are nevoie si elimina restul. Consulta medicul intotdeauna inainte de a lua orice vitamine sau suplimente. Suplimentele pot interfera uneori cu absorbtia altor medicamente, vitamine sau minerale. De asemenea, unele suplimente pot fi scumpe. Daca mananci fructe si legume pentru a obtine vitamina C in fiecare zi, cel mai probabil nu ai nevoie de suplimente de vitamina C.
2. Include vitamina D in dieta. Deficienta de vitamina D poate slabi sistemul imunitar, reducand si nivelul de limfocite.Asigura-te ca organismul primeste cel putin 600 UI(15 mcg) de vitamina D in fiecare zi. Este posibil sa nu obtii tot necesarul din dieta. Medicul va sti de ce suplimente ai nevoie.
3. Incearca vitamina E. Vitamina E sprijina productia de celule B si celule natural killer in organism. Pentru a obtine beneficii, va trebui sa iei intre 100 si 400 miligrame pe zi. Oamenii sanatosi au nevoie de mai putin, in timp ce persoanele cu probleme au nevoie de mai multa vitamina E. Aceasta este o vitamina solubila in grasimi, deci trebuie ingerata impreuna cu cel putin 3 grame de grasime. Poti obtine vitamina E din urmatoarele alimente: seminte de floarea soarelui, migdale, spanac, ulei de sofran, frunze de sfecla, dovleac conservat, ardei rosu, sparanghel, gule verde, mango, avocado si unt de arahide.
4. Adauga seleniu. Seleniul ajuta organismul sa produca mai multe globule albe. Nu e usor de obtinut prin alimentatie, asa ca sunt necesare suplimente de seleniu. Atunci cand e lua impreuna cu zincul, seleniul e si mai eficient in sustinerea functiei imunitare. Doza zilnica recomandata de seleniu pentru adulti este de 55 mcg pe zi. Daca esti insarcinata, ar trebui sa consumi 60 mcg, in timp ce , daca alaptezi, ai nevoie de un aport de 70 mcg. De asemenea, seleniul poate fi adaugat in organism prin consumul de fucte de mare, stridii, crabi si ton.
Cum sa cresti numarul de limfocite. Schimbarea stilului de viata:
1. Consulta medicul. Nivelul scazut de limfocite poate avea multe cauze, multe dintre ele temporare. De exemplu, infectiile virale, infectiile bacteriene severe si anumite antibiotice pot reduce temporar numarul de limfocite. Unele cauze, insa, sunt grave. Ne referim la anumite tipuri de cancer, boli autoimune si tulburari care reduc functia maduvei osoase. Daca banuiesti ca ai o problema grava, medicul va pune diagnosticul corect si va stabili un plan de tratament.
2. Dormi suficient. Adultii au nevoie de 7-9 ore de somn pe noapte. Adolescentii de circa 10 ore pe noapte, in timp ce copiii pot avea nevoie de pana la 13 ore. Oboseala slabeste sistemul imunitar prin reducerea numarului de globule albe din sange.
3. Redu nivelul de stres. Stresul slabeste sistemul imunitar. De asemenea, determina organismul sa secrete in exces cortizol! Astfel, organismul devine mai expus la boli, ceea ce duce si la scaderea numarului de globule albe. Pentru a reduce sreesul incearca: yoga, meditatie, plimbari in natura, respiratie adanca, hobby uri.
4. Nu mai fuma! Fumatul slabeste imunitatea, scazand numarul de celulele albe din sange.
5. Limiteaza consumul de alcool. Consumul moderat de alcool nu afecteaza sistemul imunitar. In schimb, consumul excesiv de alcool streseaza corpul, care nu mai produce suficiente celule albe.Femeile ar trebui sa se limiteze la un pahar de alcool pe zi, in timp ce barbatii ar trebui consume maximum 2 pahare.
6. Mentine o greutate sanatoasa. Daca esti prea slab/a sau supraponderal/a, celulele albe au de suferit. Organismul va produce mai putine celule albe, iar cele care exista nu vor mai functiona in parametri optimi. Mentine-ti greutatea cu o dieta echilibrata si facand exercitii fizice in mod regulat.
7. Spala-te des pe maini. Igiena corecta a mainilor reduce riscul de expunere la infectii provocate de bacterii si virusuri.
Citeste si: Ce bautura previne cancerul si omoara celulele canceroase in 3 luni

Dacă ți-a fost util,
trimite mai departe